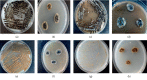

Characterization of a Halotolerant Fungus from a Marine Sponge
- PMID: 31871938
- PMCID: PMC6907059
- DOI: 10.1155/2019/3456164
Characterization of a Halotolerant Fungus from a Marine Sponge
Abstract
Introduction: Marine sponges have established symbiotic interactions with a large number of microorganisms including fungi. Most of the studies so far have focussed on the characterization of sponge-associated bacteria and archaea with only a few reports on sponge-associated fungi. During the isolation and characterization of bacteria from marine sponges of South Australia, we observed multiple types of fungi. One isolate in particular was selected for further investigation due to its unusually large size and being chromogenic. Here, we report on the investigations on the physical, morphological, chemical, and genotypic properties of this yeast-like fungus.
Methods and materials: Sponge samples were collected from South Australian marine environments, and microbes were isolated using different isolation media under various incubation conditions. Microbial isolates were identified on the basis of morphology, staining characteristics, and their 16S rRNA or ITS/28S rRNA gene sequences.
Results: Twelve types of yeast and fungal isolates were detected together with other bacteria and one of these fungi measured up to 35 μm in diameter with a unique chromogen compared to other fungi. Depending on the medium type, this unique fungal isolate appeared as yeast-like fungi with different morphological forms. The isolate can ferment and assimilate nearly all of the tested carbohydrates. Furthermore, it tolerated a high concentration of salt (up to 25%) and a range of pH and temperature. ITS and 28S rRNA gene sequencing revealed a sequence similarity of 93% and 98%, respectively, with the closest genera of Eupenidiella, Hortaea, and Stenella.
Conclusions: On the basis of its peculiar morphology, size, and genetic data, this yeast-like fungus possibly constitutes a new genus and the name Magnuscella marinae, gen nov., sp. nov., is proposed. This study is the first of its kind for the complete characterization of a yeast-like fungus from marine sponges. This novel isolate developed a symbiotic interaction with living hosts, which was not observed with other reported closest genera (they exist in a saprophytic relationship). The observed unique size and morphology may favour this new isolate to establish symbiotic interactions with living hosts.
Copyright © 2019 Yitayal S. Anteneh et al.
Conflict of interest statement
All authors declared no conflicts of interest.
Figures

References
-
- Mueller G. M., Schmit J. P. Fungal biodiversity: what do we know? What can we predict? Biodiversity and Conservation. 2007;16(1):1–5. doi: 10.1007/s10531-006-9117-7. - DOI
-
- Rodriguez R. J., Redman R. S., Henson J. M. The role of fungal symbioses in the adaptation of plants to high stress environments. Mitigation and Adaptation Strategies for Global Change. 2004;9(3):261–272. doi: 10.1023/b:miti.0000029922.31110.97. - DOI
-
- Hawksworth D. L. The magnitude of fungal diversity: the 1.5 million species estimate revisited. Mycological Research. 2001;105(12):1422–1432. doi: 10.1017/s0953756201004725. - DOI
-
- Jones E. G., Pang K.-L. Marine Fungi: and Fungal-like Organisms. Berlin, Germany: Walter de Gruyter; 2012.
MeSH terms
Substances
LinkOut - more resources
Full Text Sources
Medical